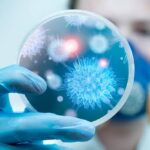

ٹیکساس: امریکا کے ایک معمر شخص نے اسکائی ڈائیونگ کر کے گینیز ورلڈ ریکارڈ اپنے نام کر لیا۔
امریکی ریاست ٹیکساس سے تعلق رکھنے والے الفریڈ ’ال‘ بلیشکے نے سب سے پہلے یہ معمر ترین اسکائی ڈائیور کا ریکارڈ 2020 میں 103 سال کی عمر میں قائم کیا تھا۔ بعد ازاں اس ریکارڈ کو سوئیڈش خاتون روت لِینیا لارسن نے 103 سال 257 دن کی عمر میں توڑا۔
الفریڈ نے یہ ریکارڈ دوبارہ حاصل کرنے کے لیے 106 برس اور 327 کی عمر میں ایک اور کوشش کی جس میں کامیاب رہے۔ اس کوشش میں ان کے ساتھ ٹیکساس حکومت کے گریگ ایبٹ نے بھی حصہ لیا۔
الفریڈ بلیشکے نے گینیز ورلڈ ریکارڈز سے بات کرتے ہوئے کہا کہ اگر آپ یہ سوچتے ہیں کہ آپ نہیں کر سکتے تو آپ خود کو کم تر سمجھ رہے ہیں۔ ہر کوئی اس سے زیادہ با صلاحیت ہوتا ہے جتنا وہ خود ہوتا ہے، انہیں بس کوشش کرنے کا فیصلہ کرنے کی ضرورت ہوتی ہے.